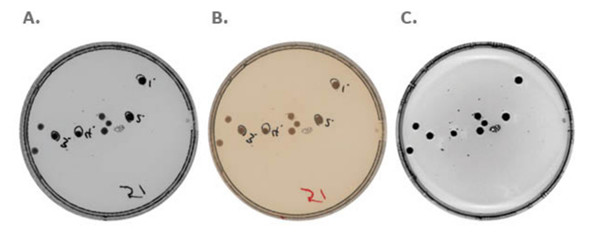
640 (4).jpg

新聞中心
在凝膠和蛋白質印跡膜中,數字電荷耦合器件 (CCD) 成像儀的主要應用都是對蛋白質和 DNA 進行成像和分析。現代 CCD 相機的靈敏度和寬動態范圍使人們對量化和便捷性充滿信心,而這些是暗室沖洗膠片所達不到的。
為了進一步完善 CCD 成像,Amersham ImageQuant 800 生物分子成像儀可減少噪聲、提高分辨率,從而提供更卓越的圖像質量。
圖像噪聲限制了可從曝光中準確分析的信號強度范圍。分辨率差會限制圖像上精細細節的展現,例如凝膠上間隔很近的條帶。ImageQuant 800 生物分子成像儀克服了這些挑戰,它采用新穎的自動曝光設置、優化信噪比觀察 (SNOW) 模式,無需像素合并即可實現高分辨率成像。
CCD 成像儀和實驗室成像的另一項挑戰是研究人員需要成像的樣品類型千差萬別,這些樣品類型需要的照明模式也迥然相異。實驗室通常有多個成像系統專門針對不同的應用,包括帶彩色標記的印跡膜發光檢測、需要 UV 照明的 DNA 凝膠、培養皿中的菌落以及多孔板中的測定。
ImageQuant 800 系統為各種樣品類型提供靈活性,還有高質量的圖像生成,這使得它在一系列應用中脫穎而出。該系統非常適合于需要已校準的 Coomassie? 染色凝膠光密度測量的質量控制實驗室,以及要求 ECL 蛋白質印跡實驗有盡可能大動態范圍的科研實驗室。
探索 ImageQuant 800 CCD 生物分子成像儀的全部功能
自動信噪比優化 提供好的圖像質量
許多實驗室 CCD 成像系統都有自動曝光模式。對于蛋白質印跡,這些模式試圖在高強度條帶飽和與低強度條帶曝光不足之間找到一個適當折中的曝光時間。結果就是動態范圍受到限制,而且很難在高強度條帶存在時對低強度條帶進行定量。當目標蛋白與高表達蛋白同時存在時,就會出現這種困難。
ImageQuant 800 系統采用獲得智能 SNOW 成像算法來自動找到信噪比 (S/N),盡量減少用戶輸入或猜測。這種方法提供了檢測低強度條帶所需的靈敏度;在傳統成像方法中,如果不增加高強度條帶的飽和度,就無法將低強度條帶可視化。
SNOW 成像模式過程涉及以下步驟:
預先曝光,確定曝光時間
選擇目標區域和背景
多次自動曝光,連續取平均值來找到信噪比
SNOW 成像模式與其他自動曝光模式的區別是,它通過捕捉多個圖像并連續進行信號平均來工作。這種圖像平均過程大程度地降低了噪聲,從而提高了信噪比(圖 1)。

圖 1. 通過 SNOW 算法進行圖像捕捉和平均,減少了噪聲,從而大限度地提高了信噪比。(A) 從第一次捕捉到捕捉 73 次后的平均值,用 SNOW 算法得出連續平均 7.5 秒曝光的曲線圖,顯示 (B) 噪聲減少且信號穩定,這使得 (C) 信噪比提高。
在 SNOW 成像過程中,用戶只輸入一次,就是在預曝光期間選擇背景和目標區域。隨后,用戶可實時觀察目標區域的信噪比不斷提高,直到系統達到信噪比。圖 2 顯示了 SNOW 過程是如何減少背景噪聲和提高信噪比的。

圖 2. 正在運行中的 ImageQuant 800 系統控制軟件和 SNOW 曝光模式。在圖像平均過程中,轉印到蛋白質印跡膜上的一系列帶 Cy5 標記的抗體稀釋液的圖像持續更新。在該圖中,信噪比接近其大值。之后,當信噪比開始降低時,SNOW 模式自動停止,軟件以大信噪比保存圖像。
使用 SNOW 算法后,無需再用傳統的試錯法來猜測找出曝光時間。這種自動化模式提高了所有目標條帶都在廣泛線性動態范圍內的幾率,不需要重復實驗或使多個印跡或 DNA 凝膠顯影,從而提高了蛋白質印跡或 DNA 凝膠工作流程的效率和生產率。圖 3 比較了對蛋白質印跡成像采用不同曝光的情況,顯示這些方法對圖像背景噪聲的不同影響。

圖 3. 在化學發光模式下對蛋白質印跡采用傳統成像方法和 SNOW 成像方法的結果比較。(A 和 B)傳統成像,曝光時間短。(C) ImageQuant 800 CCD 成像儀上運行的 93 秒 SNOW 檢測模式,采用多次短曝光并對圖像進行平均來減少噪聲。(D) 單次 93 秒曝光,不使用 SNOW 算法。與傳統成像方法相比,SNOW 檢測模式產生的線性動態范圍寬,背景噪聲小,因而能夠從更寬的信號強度范圍內對蛋白質條帶進行可視化和量化,而無需提高條帶的飽和度。
要達到這一級別的信噪比優化,不僅需要 SNOW 算法,還需要強大的光學和硬件,也就是高分辨率、830 萬像素的 CCD 相機和大光圈 F 0.74 富士? 鏡頭。ImageQuant 800 系統是 10 年持續合作的結晶,結合了富士膠片在光學領域的專業水準與我們在生命科學成像方面的專長。
通過蛋白質印跡分析更深入地了解蛋白質水平
CCD 數字成像和 X 射線膠片的另一個共同的挑戰是,在同一印跡上區分間隔緊密的條帶和多條不同的蛋白質條帶。要克服這項挑戰,通常需要以下策略:
延長聚丙烯酰胺凝膠電泳 (PAGE) 的運行時間,希望間隔緊密的條帶能夠充分分離,以便于分辨
重復蛋白質印跡實驗
進行剝離并使用其他一抗重新孵育
對于總蛋白染色,區分 Coomassie 染色凝膠上的條帶可能較為困難;不過,使用側面照明和透射白光照明結合 ImageQuant 800 CCD 成像儀的高分辨率相機,可以區分間隔僅有 0.5 mm 且分子量相似的蛋白質(圖 4A)。
為了靶向多種蛋白質,熒光蛋白質印跡提供了一種簡單的方法來替代化學發光。在雙色紅外(IR)照明功能的支持下,ImageQuant 800 系統可對同一印跡上的多種蛋白質進行多重檢測(圖 4B)。

圖 4. 在 ImageQuant 800 CCD 成像儀上通過熒光區分間隔很近的條帶與多種蛋白質的成像。(A) 對 Coomassie 染色凝膠的高分辨率比色成像展現了區分凝膠上間隔 0.5 mm 條帶的能力。(B) 對蛋白質印跡硝化纖維素膜的三色多重疊加圖像。在同一印跡上,使用長 IR(紅色)LED-濾光片組合檢測到的目標 ERK 蛋白質,以及用短 IR(綠色)LED-濾光片組合檢測到的 GAPDH。
擴大 CCD 成像儀的應用
蛋白質印跡分析是 CCD 成像儀在許多實驗室中的主要應用。盡管某些 CCD 系統可對其他應用進行成像,但這些成像儀在設計時可能沒考慮到這些應用。要適應這些場景,可能需要更改硬件和設置,這會使工作流程變得復雜。此外,也可能損害圖像質量或靈敏度。
相比之下,ImageQuant 800 CCD 成像儀可簡化并提供適合廣泛應用的高質量圖像,而且內置了靈活的照明選項和廣泛的適用樣品類型。比如,光源模式包括:
側面白光(470 nm 至 656 nm)
側面 UV (360 nm)
側面 RGB(635 nm、460 nm 和 535 nm)
側面短 IR (660 nm)
側面長 IR (775 nm)
透射白光
借助這些照明選項和各種可自定義的濾光片,用戶使用一臺儀器就能對各種樣品進行全光譜成像。這種靈活性使得用戶能夠完成一系列有用的研究功能和應用,同時節省空間并簡化工作流程。
菌落計數和分析
對細胞菌落進行計數可能很乏味,也很耗時。菌落計數系統在提供一個非常特殊的功能的同時占用了工作臺的空間。此外,使用標準手持相機對不同的培養皿再現相同的圖像和分析可能存在挑戰。
ImageQuant 800 CCD 成像儀軟件利用了照明靈活性,能夠使用光密度 (OD)、熒光或 UV 模式實現自動菌落分析(圖 5)。利用附加的無視差 (NP) 鏡頭配件,可無需引入光學工件,即將化學發光成像用于培養皿和多孔板。
圖 5. 使用 ImageQuant 800 系統為培養皿提供菌落成像選項。(A) 光密度測量提供對每個菌落 OD 的直接測量。(B) 全彩成像。(C) 側面 UV 熒光成像用于捕捉細胞的自發熒光。使用 NP 鏡頭配件盤還可進行化學發光成像。
宿主細胞蛋白分析
宿主細胞蛋白 (HCP) 水平為生物制品提供了一個純度指標,這樣制造商就能評估其純化策略并遵從藥典建議。HCP 分析是獲得監管機構批準的關鍵一步。
要分析 HCP ELISA,通常需要單獨的微孔板分光光度計。不過,如果使用 ImageQuant 800 系統上的 ImageQuant TL 分析軟件,無需專用的板讀取器就能分析 HCP ELISA(圖 6)。

圖 6. 使用 HCPQuant ELISA 試劑盒和 ImageQuant 800 CCD 成像儀對 HCP ELISA 的結果分析。(A) 白光圖像顯示在從中國倉鼠卵巢 (CHO) 細胞中檢測到 HCP 蛋白后,顏色變為黃色。(B) 陣列分析圖像,其中提供適當的參照樣本;(C) 由軟件生成的用于量化的標準曲線。
作為其化學發光和熒光蛋白質印跡成像模式的延伸,ImageQuant 800 CCD 成像儀提供對 HCP 覆蓋率測定的直接成像。可使用傳統的蛋白質印跡、差異印跡電泳 (DIBE) 或差異凝膠電泳 (DIGE) 方法進行這些測定。
DNA 凝膠可視化和宏觀成像應用
對 DNA 凝膠進行成像的傳統方法是采用專用的 UV 平臺,再連接計算機、相機和打印機。ImageQuant 800 因為具有 UV 照明模式,不需要單獨的設備,生成的圖像文件使用 ImageQuant CONNECT 軟件從本地和遠程均可輕松訪問。
ImageQuant 800 系統非常通用,不僅限于實驗室凝膠、印跡和孔板。例如,UV 照明功能已被用于研究宏觀層面的結構,比如熒光激發下花朵上呈現的脈絡狀圖案(圖 7)。1

圖 7. 采用不同的 LED 和濾光片組合在 ImageQuant 800 系統中成像的石斛蘭花。成像儀展示了花朵各部分在不同的激發波長下的熒光效果,呈現出脈絡狀圖案。
充分利用 CCD 成像儀
將多個成像儀器組合到一個 CCD 成像系統中可能會引起對儀器可用性的擔憂,尤其是在多用戶的實驗室中。如果某臺儀器不可用或者需求量很大,就有可能限制研究人員,造成與儀器使用有關的瓶頸。
ImageQuant 800 CCD 成像儀和相關的 ImageQuant CONNECT 軟件在設計中考慮到了這些挑戰。連接到本地網絡后,可在本地和遠程調度系統軟件,還能訪問之前運行所得到的圖像。由于可輕易訪問圖像,不再需要使用 USB 驅動器進行物理傳輸。
CCD 成像儀可隨著實驗室的研究需求而改進
對于任何實驗室或研究機構來說,CCD 成像儀都是一項重大投資。想滿足實驗室不斷變化的研究需求,又想避免設備閑置,要在這兩者之間達到平衡可能具有挑戰性。
ImageQuant 800 生物分子成像儀具備多種功能,即使實驗室不需要全套選項,也能從高分辨率、高質量和高度精準的圖像中獲益。該系統提供 4 種配置:ImageQuant 800、ImageQuant 800 UV、ImageQuant 800 OD 和 ImageQuant 800 Fluor。表 1 中描述了每種配置的應用和光源。每個選項都提供直接升級途徑,可擴展和調整來適應研究小組隨時間變化的獨特需求。
表 1. ImageQuant 800 系統配置和應用

